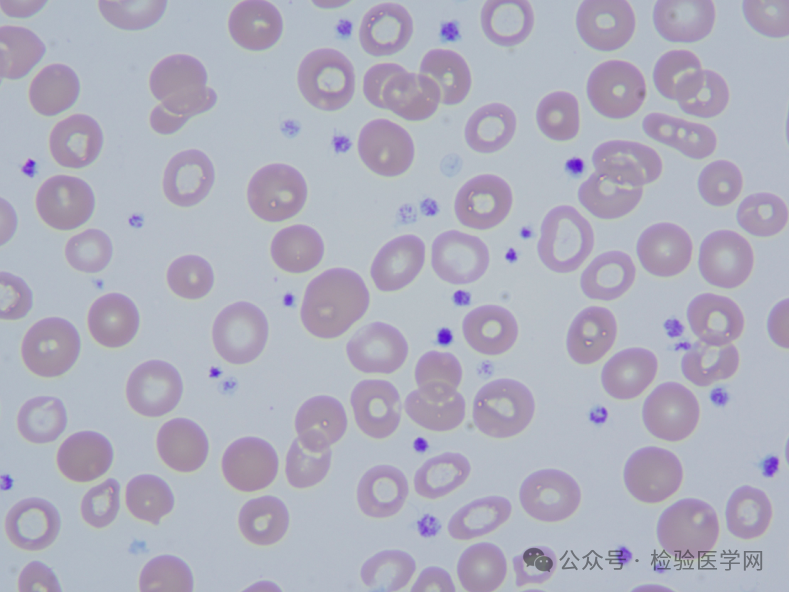
涂片瑞士吉姆萨染色,1000倍油镜下,结果如图5,镜下血小板增多,散在

1000倍镜怎么画

显微镜图片_显微镜高清图片_全景视觉
图片尺寸670x670
显微镜简笔画
图片尺寸469x474
八倍镜简笔画
图片尺寸900x600
显微镜下东西的简笔画
图片尺寸500x500
如何绘制显微镜
图片尺寸500x362
显微镜简笔画图片
图片尺寸1200x1200
瞄准镜简笔画怎么画
图片尺寸500x747
下图是显微镜的结构示意图,请据图回答
图片尺寸176x212
吃鸡玩家把战令枪升满级开心没几分钟打开倍镜后悔了
图片尺寸1000x586
显微镜怎么画
图片尺寸800x533
光学显微镜结构图简笔画
图片尺寸324x450
绝地求生高中生手绘倍镜八倍很逼真有一个细节没到位
图片尺寸1000x673![关键词 : 手绘显微镜,免费矢量下载,矢量图,插画[声明] 觅元素所有](https://imgs.wantubizhi.com/img/735A5D1F980B52A636CC46F12F2D1A732DFAF5ADC737FB6937B4E4BCAAF10EFC4C61336688D3D92856B66F2FA05F7A9308D8550BD8C1979835D4C5212CAF508CD6FB702119B74544B44F3B56159F66832A5FCDB28D3C2FB3F00E80D1C528D17D)
关键词 : 手绘显微镜,免费矢量下载,矢量图,插画[声明] 觅元素所有
图片尺寸610x962
镜观天下视力保护中心 金氏眼镜行 五.一
图片尺寸1080x1920
显微镜简笔画
图片尺寸554x493
显微镜画法 显微镜怎么画-养娃家
图片尺寸700x525
显微镜怎么画
图片尺寸800x533
涂片瑞士吉姆萨染色,1000倍油镜下,结果如图5,镜下血小板增多,散在
图片尺寸789x592
激光前沿 -合束技术提高蓝光半导体激光器的功率和亮度
图片尺寸287x325
显微镜怎么画
图片尺寸1280x720











![关键词 : 手绘显微镜,免费矢量下载,矢量图,插画[声明] 觅元素所有](https://imgs.wantubizhi.com/img/735A5D1F980B52A636CC46F12F2D1A732DFAF5ADC737FB6937B4E4BCAAF10EFC4C61336688D3D92856B66F2FA05F7A9308D8550BD8C1979835D4C5212CAF508CD6FB702119B74544B44F3B56159F66832A5FCDB28D3C2FB3F00E80D1C528D17D)



















![关键词 : 手绘显微镜,免费矢量下载,矢量图,插画[声明] 觅元素所有](https://bpic.51yuansu.com/pic3/cover/02/01/71/599d1bff126b1_610.jpg)